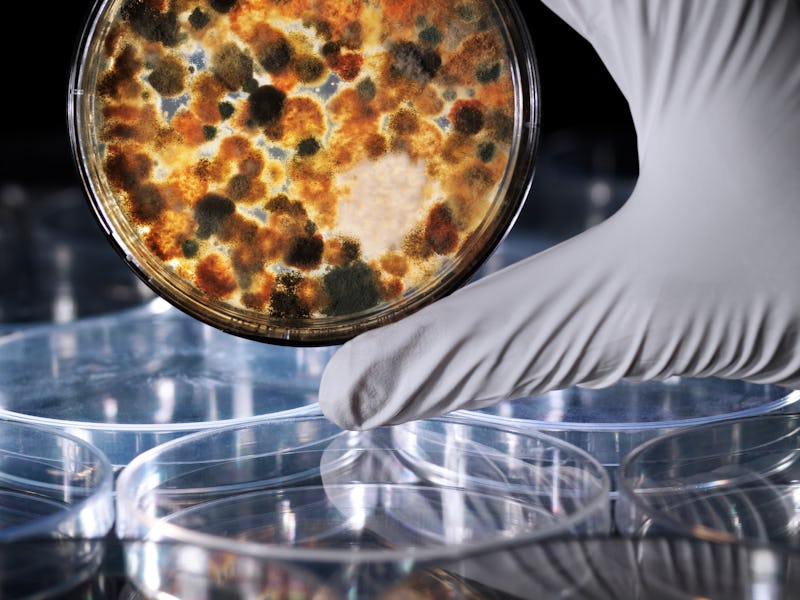

Mysterious Chernobyl fungus could protect future astronauts
Could the future of spaceflight be mushrooms?
A lack of effective radiation shielding is one of the biggest challenges still to be overcome if humans are to embark on long-term voyages into deep space. On Earth, the planet’s powerful magnetosphere protects us from the deadliest forms of radiation — those produced by solar flares, and galactic cosmic rays arriving from afar — that stream through the Solar System.
Astronauts on the International Space Station, some 408km above the Earth, receive elevated levels of radiation but are close enough to Earth that they still receive some shielding, and can stay in orbit for up to a year. The same can’t be said for astronauts traveling further out, to the Moon, for example, or, someday, to Mars. Future deep space voyagers will need to bring their own shielding with them — or, as a new paper suggests — grow it along the way.
According to the paper, published in pre-print format on BioRxiv earlier this month, a special type of fungi that thrives in high radiation environments called Cladosporium sphaerospermum could form a living shield around astronauts in space. The fungus not only blocks radiation but actually uses it to grow, through a process call radiosynthesis: it pulls energy from radiation, just as most plants pull energy from sunlight via photosynthesis.
“Over the period of one year, the average person on Earth is dosed with about 6.2 mSv, while the average astronaut on the International Space Station (ISS) is exposed to an equivalent of approximately 144 mSv; one year into a three-year mission to Mars, an astronaut would already have accumulated some 400 mSv.” — Graham Shunk et al., BioRxiv.
These radiation-loving fungi survive on Earth in extreme places, like the site of the Chernobyl Nuclear Power Plant in Ukraine. In space, they do just as well. In 2019, researchers flew some of the fungi to the ISS, watching how it grew over a period of 30 days, and measuring the amount of radiation that passed through it, as compared to a control sample with no fungi.
The experiment showed that radiation levels beneath a 1.7mm thick bed of fungus were about 2.17 percent lower than the control. Not only that, but the fungus grew about 21 percent faster than it does on Earth, meaning that the fungi’s ability to act as a protective shield for astronauts could actually grow more robust the longer a mission lasts.
Cladosporium sphaerospermum, a radiotrophic fungus, could act as a radiation shield on deep space missions.
It’s too early to get overly excited about the practical applications of this fungus in space travel. The team estimates that on Mars, to bring radiation levels down to Earth-like conditions, a habitat would need to be covered with a 2.3-meter thick layer of radiosynthesizing fungi. The same effect could be achieved by burying the habitat beneath 3 meters of Martian dirt (regolith). Still, the potential for biological solutions to what are often considered engineering challenges is a unique approach and may prove fruitful.
In the near future, astronauts will rely on more mundane solutions. In the case of solar flare events, contingency plans involve sheltering amidst a spaceship’s cargo: the more mass between the astronauts and the incoming radiation, the safer they’ll be. The upcoming uncrewed Artemis 1 mission, due to launch next year, is testing a protective vest designed to minimize the radiation doses received by the wearer.
So far, none of these solutions are ideal. There is a lot of work still to be done to keep future astronauts safe. When the time comes, however, don’t be surprised if part of the solution to space radiation involves hiding beneath a thick blanket of friendly fungi.
This article was originally published on Universe Today by Scott Alan Johnston. Read the original article here.
This article was originally published on